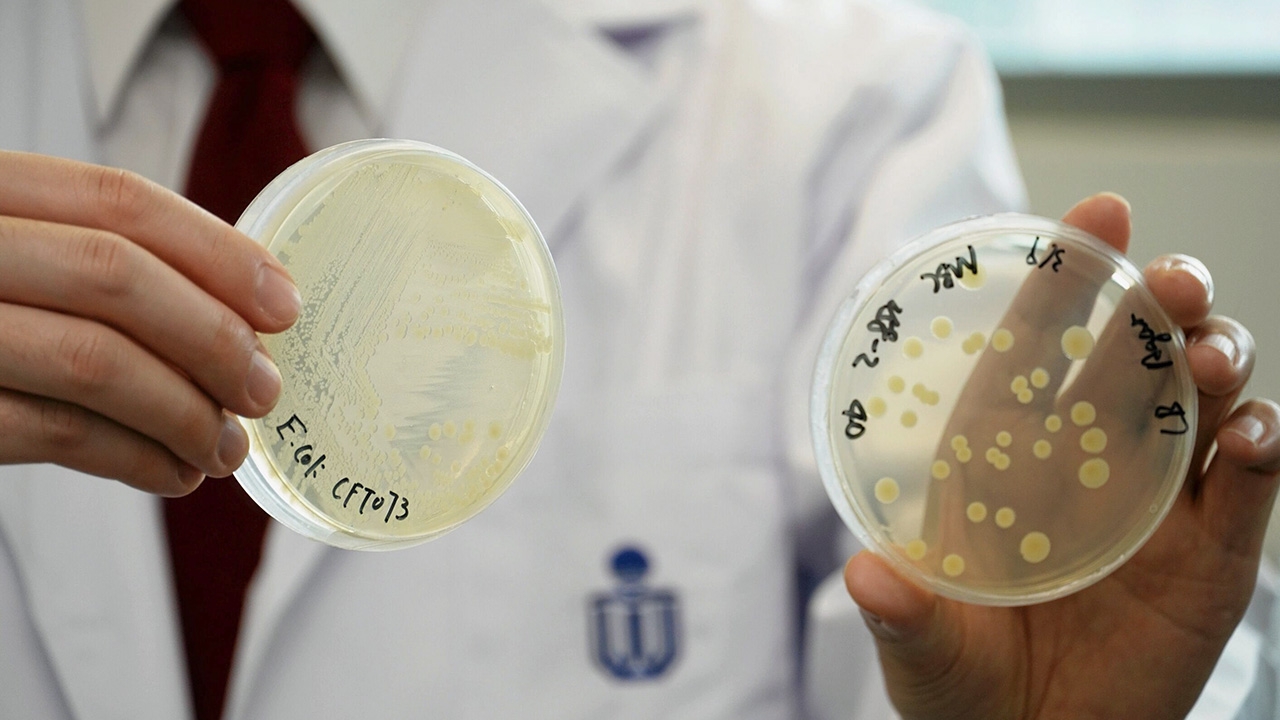

(ภาพ)Credit : Hong Kong University of Science and Technology
ทีมวิจัยสหวิชาชีพจากมหาวิทยาลัยวิทยาศาสตร์และเทคโนโลยีฮ่องกง (HKUST) รายงานเมื่อเร็วๆนี้ว่า สารพิษที่ปล่อยออกมาจากเชื้อเอสเชอริเชีย โคไล หรือ อี.โคไล (Escherichia coli–E. coli) ซึ่งเป็นแบคทีเรียในลำไส้ของมนุษย์ มีความเชื่อมโยงกับมะเร็งลำไส้ใหญ่ ถึงแม้ อี.โคไลจะช่วยย่อยอาหารและควบคุมระบบภูมิคุ้มกันในร่างกายคนเรา แต่มันยังมีสารพิษชื่อโคลีแบคติน (colibactin) เป็นสารก่อมะเร็งที่ก่อกวนวัฏจักรของเซลล์และทำให้เซลล์ตายในที่สุด
ทว่าสารโคลีแบคตินที่ก่อให้เกิดความเสียหายกับดีเอ็นเอยังคงเป็นปริศนา แต่ในที่สุดทีมวิจัยก็ค้นพบการเชื่อมโยงที่ขาดหายไปของสารพิษโคลีแบคติน จากการใช้วิธีสังเคราะห์ทางชีวภาพแบบใหม่ซึ่งประสบความสำเร็จในการโคลนยีนโคลิแบคติน และพบวิธีที่จะสร้างยีนจำนวนมากเพื่อใช้ทดสอบและตรวจสอบความถูกต้อง ทีมเผยว่าหลังจากตรวจสารตั้งต้นของโคลีแบคตินซ้ำหลายครั้งก็ระบุว่าได้ “โคลีแบคติน-645” (colibactin-645) เป็นตัวการสำคัญของการแตกตัวของสายดีเอ็นเอเกลียวคู่ในเซลล์ยูคาริโอต ทำให้เพิ่มความเสี่ยงต่อการเกิดมะเร็งลำไส้ใหญ่
นอกจากนี้ยังล่วงรู้ถึงเส้นทางชีวสังเคราะห์ของสารพิษดังกล่าว รวมถึงกลไกในการทำลายดีเอ็นเอ ซึ่งนักวิจัยมองว่าแบคทีเรีย อี.โคไลจะเป็นตัวช่วยการวิจัยในอนาคต เกี่ยวกับการป้องกันโรคมะเร็งที่พบมากที่สุดเป็นอันดับ 3 ของโลก.